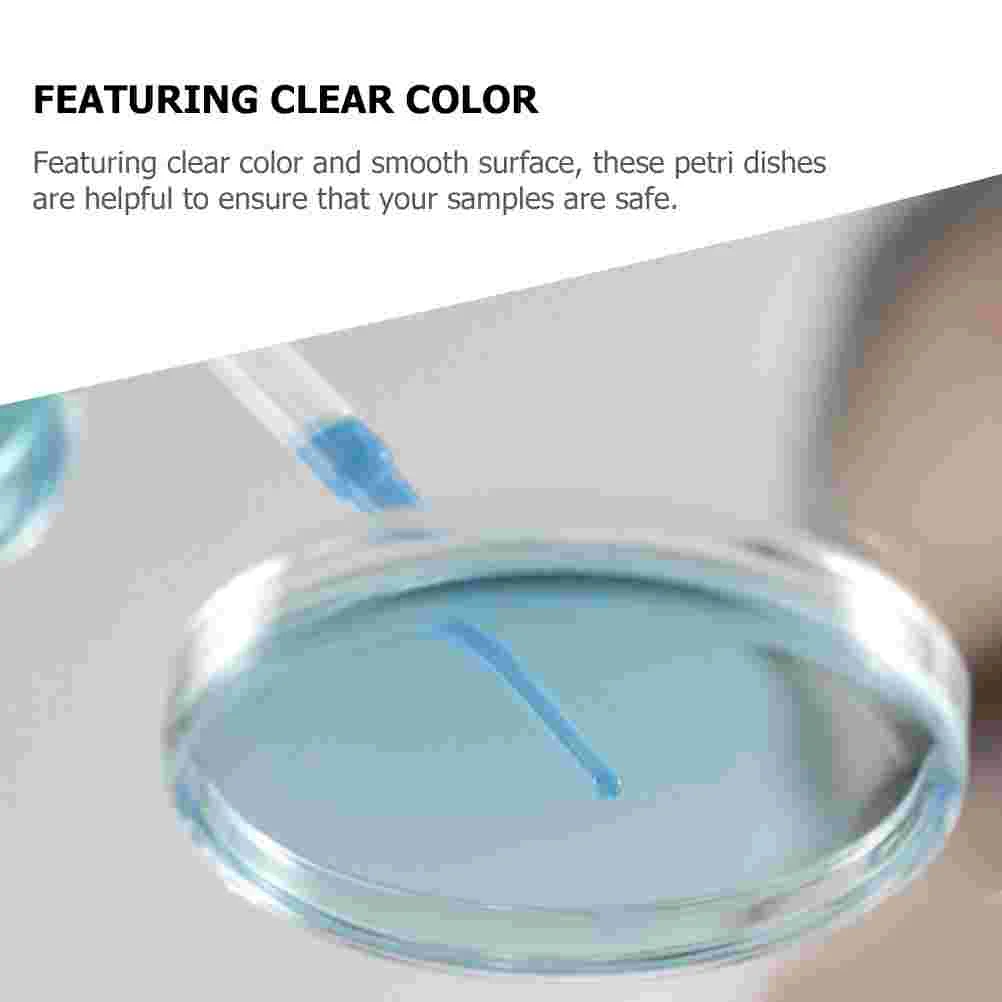
thumb

10 шт. тарелка для культивирования, пластиковая чашка Петри, научные блюда, одноразовая для экспериментов с крышками, агаровая салфетка
Price history chart & currency exchange rate
Customers also viewed

$183.27
Y-3 однотонные повседневные шорты с эластичной талией и пятью точками, женские шорты черного цвета IR6253
joom.com
$86.03
Коврик для ванной Kleine Wolke "Луг", высота 30 мм, с противоскользящим покрытием, подходит для пола с подогревом, коврик для ванной, однотонный прямоугольный (70х120 см), цвет grey steel
cdek.shopping
$1.42
4Pcs Face Sticker Books Develop Children's Imagination or Creativity Each Book Include 12 Face and 100+ Stickers Children Craft
aliexpress.com
$23.38
1 Roll of 6M Plastic Safety Chain Sun Shield UV Resistant Plastic Chain Hangers Colored Barrier Chain Belt for Construction
aliexpress.com
$19.79
H Han Queen Autumn Winter Simple Basic Lattice Knitted Cardigans Sweaters Women Tops V-Neck Vintage Loose Long Sleeve Sweater
aliexpress.com
$14.11
Naruto Anime Figure Uchiha Itachi Pvc Action Figure Toy Naruto Shippuden Uchiha Itachi And Crow Collection Model Toy 25cm
aliexpress.com
$17.08
Ornaments Home Desktop Decor Decorative Heart Style Bedroom Resin Crafts Finger Statue Adornments Lovers Prime
aliexpress.com
$17.43
36/72/90W Nail Dryer LED Lamp for Curing All Kinds of UV Gel/Polish/Varnish with Timer Auto Sensor All of Manicure/Pedicure Tool
aliexpress.com
$17.15
Gothic Girl Red Rose Pattern Women's Male Autu Winter Soft Sneakers Non-slip Durable Round Toe Casual Shoes Dirt Resistant Flats
aliexpress.com
$27.42
Sofa Throw Pillows Triangular Reading Pillow Bedside Soft Large Backrest Waist Cushion Dormitory Bed Back Cushion Office Pillow
aliexpress.com
$3.87
Fuel Filter Fit For MTD Troy-Bilt Cub Cadet Yard-Man BS-691035, BS-695666 and BS-493629 TORO 181520 2505007-S Jacobsen 5000436
aliexpress.com
$2.78
Alf Hot Sale Backpack Fashion Bags Life Form Puppet Sitcom 80S Nostalgic Tv Show Series Humour Romantic Alf Red Rose Funny Film
aliexpress.com
$1.16
Colorful Crescent Moon Stars Face Gems Temporary Tattoos Eyes Eyeshadow Rhinestones Jewels Makeup Sticker 3D Heart Jewelry Party
aliexpress.com
$77.79
ansio Bento Fluffy and Easy to Made in Dishwasher Microwave Safe Box, Wash, 500ml, Green, Japan, Safe,
joom.com
$6.25
New Product: A 925 Sterling Silver Minimalist And Fashionable Freshwater Pearl Pendant Necklace, Elegant And Versatile, Suitable For Daily Wear As A Jewelry Gift For Women
temu.com
$52.21
fashion thick bottom sandals summer high heels women elegant breathable mesh shoes woman, Black
dhgate.com
$18.02
sparkling clear blue elevated heart ring women anel feminino 100% 925 jewelry sterling silver anillos mujer wedding bagues cluster rings, Golden;silver
dhgate.com
$6.27
stud migga 2021 trendy cubic zirconia star earrings gold color cz crystal fashion women jewelry, Golden;silver
dhgate.com
$22.05
Detachable Dark Red Microfiber Leather Hand Pillow Rest Manicure Table Hand Cushion Pillow Holder Armrests Nail Art Stand Desk
aliexpress.com
$26.46
Unisex Classic Brand Men Aluminum Sunglasses HD Polarized UV400 Mirror Male Sun Glasses Women For Men M2431
dhgate.com
$27.33
Chain Women Necklaces Gold Color Charms Jewelry Trendy 50CM 3MM Men Vintage Necklace N215 Chains, Silver
dhgate.com
$3.74
I Love You Morse Code Bracelet Couples Matching Bracelets Adjustable Handmade Braided Black Rope Bracelet Couple Friend Jewelry
dhgate.com
$25.16
Western Style Cowboy/ Cowgirl Straw Hat Beach Panama Sun Hats Women & Men Braid Straw Hat with Adjustable Chin Strap, White
dhgate.com